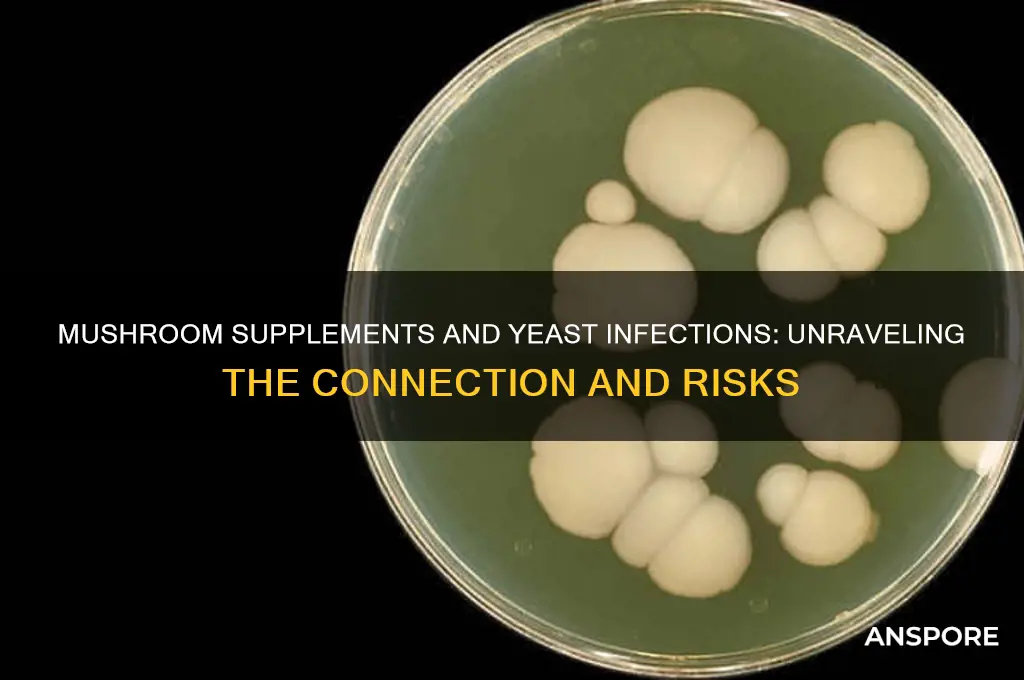
can mushroom supplements cause yeast infections

Mushroom supplements have gained popularity for their potential health benefits, including immune support and stress reduction, but concerns have arisen regarding their possible link to yeast infections. While mushrooms themselves are fungi, the connection between mushroom supplements and yeast infections is not well-established. Some theories suggest that certain mushroom species or their extracts might disrupt the body’s natural microbial balance, potentially promoting the overgrowth of *Candida*, the fungus responsible for yeast infections. However, scientific evidence supporting this claim remains limited, and individual responses to supplements can vary. Factors such as pre-existing conditions, dosage, and the specific type of mushroom supplement may play a role. As with any dietary supplement, consulting a healthcare professional is advisable to ensure safety and address personal health concerns.
| Characteristics | Values |
|---|---|
| Direct Causation | No conclusive evidence that mushroom supplements directly cause yeast infections. |
| Immune System Impact | Some mushrooms (e.g., Reishi, Chaga) may modulate the immune system, potentially affecting susceptibility to infections, but this is not specific to yeast infections. |
| Gut Microbiome Influence | Mushrooms can alter gut flora, which might indirectly impact yeast balance, but no direct link to causing yeast infections. |
| Sugar Content | Most mushroom supplements are low in sugar, reducing the likelihood of promoting yeast overgrowth. |
| Individual Sensitivity | Rare cases of allergic reactions or sensitivities to mushrooms may disrupt microbial balance, but this is not a common cause of yeast infections. |
| Scientific Studies | Limited research specifically linking mushroom supplements to yeast infections. Existing studies focus on immune support, not fungal overgrowth. |
| Expert Consensus | No consensus among healthcare professionals that mushroom supplements are a risk factor for yeast infections. |
| Preexisting Conditions | Individuals with compromised immune systems or preexisting yeast imbalances may be more susceptible, but this is not exclusive to mushroom supplements. |
| Common Misconception | Mushrooms are often confused with fungi like yeast, but edible mushrooms and yeast (Candida) are distinct organisms with different effects on the body. |
| Prevention vs. Causation | Some mushrooms (e.g., Turkey Tail) may help prevent yeast infections by supporting immune function, but they are not known to cause them. |
| Dosage and Quality | Overconsumption or low-quality supplements might theoretically impact health, but no evidence links this to yeast infections specifically. |
| Conclusion | Mushroom supplements are unlikely to cause yeast infections. Individual reactions may vary, but no direct causation is supported by current data. |
Explore related products
What You'll Learn

Mushroom Supplements and Candida Overgrowth
Mushroom supplements, often hailed for their immune-boosting and anti-inflammatory properties, have gained popularity in wellness circles. However, concerns arise regarding their potential to disrupt microbial balance, particularly in relation to Candida overgrowth. Candida, a type of yeast naturally present in the body, can proliferate excessively under certain conditions, leading to infections. While mushrooms themselves are fungi, their impact on Candida is not straightforward. Some mushrooms, like reishi and turkey tail, possess antimicrobial properties that may inhibit Candida growth. Conversely, others, such as shiitake or maitake, could theoretically stimulate fungal activity due to their mycelial nature. Understanding this duality is crucial for those considering mushroom supplements, especially individuals with a history of yeast infections or compromised immune systems.
Analyzing the mechanisms at play, mushroom supplements often contain beta-glucans, compounds known to modulate the immune system. While this can enhance overall immunity, an overactive immune response might inadvertently create an environment conducive to Candida overgrowth. For instance, excessive immune stimulation could disrupt gut flora, reducing the presence of beneficial bacteria that typically keep Candida in check. Dosage plays a critical role here; exceeding recommended intake (e.g., 500–1,000 mg daily for reishi extract) may increase risk. Additionally, the form of the supplement matters—powders or capsules derived from mycelium grown on grain may contain residual starch, a potential food source for Candida. Opting for fruiting body-only products can mitigate this risk.
For those prone to yeast infections, a cautious approach is warranted. Start with low doses and monitor symptoms for 2–3 weeks. Incorporate probiotics (e.g., Lactobacillus acidophilus) alongside mushroom supplements to maintain gut balance. Avoid combining mushrooms with high-sugar diets, as sugar fuels Candida growth. Pregnant or immunocompromised individuals should consult healthcare providers before use, as their bodies may respond differently. Practical tips include choosing organic, third-party tested supplements and rotating mushroom types to prevent tolerance or adverse effects. For example, alternating between reishi and lion’s mane every 2–3 months can provide balanced benefits without overstimulating the system.
Comparatively, mushroom supplements differ from conventional antifungals like fluconazole, which directly target Candida but may disrupt gut flora. Mushrooms offer a more holistic approach, supporting immunity while potentially addressing underlying imbalances. However, their indirect action means results are less predictable. Case studies suggest that individuals with recurrent yeast infections may benefit from combining mushroom supplements with dietary changes (e.g., reducing refined carbs) and topical treatments like caprylic acid. This multi-pronged strategy addresses both the symptoms and root causes of Candida overgrowth.
In conclusion, while mushroom supplements are not a direct cause of yeast infections, their interaction with Candida is nuanced. Their immune-modulating and antimicrobial properties can either suppress or inadvertently promote overgrowth, depending on factors like dosage, form, and individual health status. By adopting a mindful approach—starting with low doses, pairing with probiotics, and avoiding starch-based products—users can harness their benefits while minimizing risks. As with any supplement, personalization and vigilance are key to achieving optimal outcomes without unintended consequences.
Post-Mushroom Insomnia: Why Can't You Sleep After Eating Mushrooms?
You may want to see also

Immune Impact of Mushroom Supplements
Mushroom supplements, often hailed for their immune-boosting properties, contain beta-glucans and other bioactive compounds that modulate immune function. While these substances can enhance the body’s defense mechanisms, their impact on microbial balance—particularly in relation to yeast infections—warrants scrutiny. Beta-glucans stimulate immune cells like macrophages and natural killer cells, which may inadvertently create an environment where opportunistic pathogens, such as *Candida albicans*, could thrive if the immune response is dysregulated. This paradox highlights the need to understand how mushroom supplements interact with the immune system and microbial flora.
Consider the dosage and type of mushroom supplement when evaluating immune impact. For instance, reishi (*Ganoderma lucidum*) and turkey tail (*Trametes versicolor*) are commonly used for their immunomodulatory effects. A typical dose of 1–3 grams daily of reishi extract may strengthen immune responses, but excessive intake could overstimulate the immune system, potentially disrupting gut microbiota equilibrium. Similarly, turkey tail supplements, often dosed at 2–3 grams daily, support immune function but require careful monitoring in individuals with pre-existing immune imbalances. Always consult a healthcare provider to tailor dosage to your specific needs.
Practical tips can mitigate risks while maximizing benefits. Pair mushroom supplements with prebiotic-rich foods like garlic, onions, or chicory root to support beneficial gut bacteria, which can counteract yeast overgrowth. Avoid taking high doses of immune-stimulating mushrooms during active infections, as this may exacerbate symptoms. For individuals prone to yeast infections, alternating mushroom supplements with antifungal herbs like oregano oil or caprylic acid could provide a balanced approach. Hydration and a low-sugar diet further reduce the risk of *Candida* proliferation.
Comparatively, mushroom supplements differ from conventional immune boosters like vitamin C or zinc in their mechanism of action. While vitamins directly support immune cell function, mushrooms act indirectly by modulating cytokine production and immune signaling pathways. This nuanced effect means their impact on yeast infections is less predictable. For example, cordyceps (*Cordyceps sinensis*), known for its energizing properties, may enhance immune surveillance but could also increase inflammation if overused. Understanding these distinctions helps users make informed choices tailored to their health goals and vulnerabilities.
In conclusion, the immune impact of mushroom supplements is a double-edged sword, offering both protection and potential disruption to microbial balance. By focusing on dosage, type, and complementary strategies, individuals can harness their benefits while minimizing the risk of yeast infections. Always approach supplementation with awareness of your body’s unique responses and consult a professional for personalized guidance.
Sliced Mushrooms: Avoiding Mushy Results in Cooking and Storage
You may want to see also

Probiotic vs. Prebiotic Effects
Mushroom supplements, often hailed for their immune-boosting and anti-inflammatory properties, have sparked concerns about their potential to cause yeast infections. While mushrooms themselves are fungi, their impact on the body’s microbial balance is complex. Understanding the role of probiotics and prebiotics in this equation is crucial, as they directly influence gut health and, by extension, the risk of yeast overgrowth.
Probiotics, often referred to as "good bacteria," are live microorganisms that support a healthy gut microbiome. Common strains like *Lactobacillus acidophilus* and *Bifidobacterium* are known to inhibit the growth of *Candida albicans*, the fungus responsible for yeast infections. Incorporating probiotic-rich foods (e.g., yogurt, kefir) or supplements (10–50 billion CFUs daily for adults) can help maintain microbial balance. However, mushroom supplements, particularly those containing beta-glucans, may stimulate the immune system in ways that indirectly support probiotic activity. This synergy suggests that mushrooms could complement probiotics rather than disrupt them, reducing the likelihood of yeast infections.
Prebiotics, on the other hand, are non-digestible fibers that feed beneficial gut bacteria. Examples include inulin, found in chicory root, and beta-glucans, abundant in certain mushrooms like reishi and maitake. While prebiotics promote the growth of probiotics, they can also inadvertently nourish opportunistic fungi like *Candida* if the microbiome is already imbalanced. For instance, individuals with compromised gut health or those taking high doses of prebiotic-rich mushroom supplements (e.g., 500–1,000 mg daily) may experience a shift in microbial dynamics, potentially favoring yeast overgrowth. This highlights the importance of balancing prebiotic intake with probiotic support.
A comparative analysis reveals that the probiotic-prebiotic interplay is delicate. Probiotics actively combat yeast infections by competing for resources and producing antimicrobial compounds, whereas prebiotics can either support or exacerbate the issue depending on the gut environment. For those using mushroom supplements, pairing them with probiotic strains like *Saccharomyces boulardii* (a yeast-based probiotic) can mitigate risks. Additionally, monitoring prebiotic dosage and starting with lower amounts (2–5 grams daily) can prevent unintended fungal proliferation.
In practice, individuals concerned about yeast infections should adopt a dual strategy: incorporate probiotics to directly inhibit *Candida* and use prebiotic-rich mushroom supplements judiciously. For example, combining a daily probiotic capsule with a moderate dose of lion’s mane or chaga extract can harness their benefits without tipping the microbial scale. Age-specific considerations are also important; older adults or those with weakened immunity may require lower prebiotic doses and higher probiotic CFUs to maintain equilibrium. By understanding these dynamics, mushroom supplement users can enjoy their benefits while safeguarding against yeast infections.
Consecutive Mushroom Consumption: Risks and Considerations for Safe Usage
You may want to see also
Explore related products

Sugar Content in Supplements
Mushroom supplements, often marketed for immune support and overall wellness, can inadvertently contribute to yeast infections due to their sugar content. Many manufacturers add sugars like maltodextrin, dextrose, or fructose as fillers or flavor enhancers, creating an environment conducive to Candida overgrowth. Even small amounts—as little as 2–5 grams per serving—can disrupt the delicate balance of gut flora, especially in individuals with preexisting conditions like diabetes or compromised immunity. Always scrutinize the "Other Ingredients" section on labels, as sugars may be listed under innocuous-sounding names.
Consider the dosage and frequency of consumption. A single supplement might seem harmless, but stacking multiple products (e.g., mushroom capsules, protein powders, or multivitamins) can lead to cumulative sugar intake. For instance, if one mushroom supplement contains 3 grams of sugar per serving and you take it twice daily, that’s 6 grams of sugar solely from that source. Pair this with a sugary probiotic or pre-workout, and you’re inadvertently feeding yeast. To mitigate risk, limit daily added sugar intake to under 25 grams for women and 36 grams for men, as recommended by the American Heart Association, and account for all sources, including supplements.
Not all mushroom supplements are created equal. Some brands prioritize purity, using organic mushrooms with no added sugars or fillers. Look for products labeled "pure extract" or "fruiting body only," which typically contain less than 1 gram of naturally occurring sugars per serving. Alternatively, opt for tinctures or powders that use alcohol or water-based extraction methods, which eliminate the need for sugar additives. For those with yeast sensitivities, consulting a healthcare provider for personalized recommendations is advisable, especially when combining supplements with antifungal treatments.
Practical tips can further reduce risk. If you suspect a supplement is contributing to yeast issues, try a 2-week elimination test: discontinue use and monitor symptoms. Reintroduce the product afterward to assess its impact. Additionally, pair mushroom supplements with sugar-free probiotics containing Saccharomyces boulardii, which competes with Candida for resources. Finally, store supplements properly—moisture or heat can degrade ingredients, potentially increasing sugar availability. By staying vigilant about sugar content, you can enjoy the benefits of mushroom supplements without compromising fungal balance.
Can King Stropharia Mushrooms Neutralize Sodium Chloride? Exploring the Science
You may want to see also

Individual Sensitivity and Risk Factors
While there’s no definitive evidence linking mushroom supplements directly to yeast infections, individual sensitivity plays a critical role in how these supplements interact with the body. Some mushrooms, like reishi or lion’s mane, contain beta-glucans, compounds that can modulate the immune system. For individuals with pre-existing immune imbalances or sensitivities, this modulation might disrupt the body’s natural fungal flora, potentially creating an environment conducive to yeast overgrowth. For instance, a person with a history of recurrent yeast infections might find that high doses (e.g., 1,000–2,000 mg daily) of these supplements exacerbate their condition, even if they’re beneficial for others.
Consider the role of gut health in this equation. Mushroom supplements often act as prebiotics, feeding beneficial gut bacteria. However, in individuals with dysbiosis (an imbalance of gut microbes), this prebiotic effect could inadvertently nourish Candida, the fungus responsible for yeast infections. A 2021 study suggested that individuals with small intestinal bacterial overgrowth (SIBO) might be more susceptible to this effect. Practical advice? Start with a low dose (500 mg daily) and monitor symptoms. If itching, bloating, or discharge occurs, discontinue use and consult a healthcare provider.
Age and hormonal status further complicate the picture. Women of reproductive age, particularly those on hormonal birth control or experiencing menopause, are already at higher risk for yeast infections due to estrogen fluctuations. Mushroom supplements that influence estrogen metabolism, such as maitake or shiitake, could theoretically tip the balance. For example, postmenopausal women taking 1,000 mg of maitake extract daily reported increased vaginal discomfort in anecdotal reports, though clinical studies remain limited. If you fall into this demographic, pair mushroom supplements with probiotics containing Lactobacillus strains to support vaginal health.
Finally, lifestyle factors cannot be overlooked. High-sugar diets, antibiotic use, and stress weaken the body’s defenses against yeast overgrowth, amplifying the potential risk from mushroom supplements. A 30-year-old woman with a history of yeast infections, taking antibiotics for a sinus infection, might find that adding a mushroom supplement during this time triggers a recurrence. The takeaway? Context matters. Assess your overall health, current medications, and dietary habits before incorporating mushroom supplements. When in doubt, a 7-day trial at a minimal dose can help identify sensitivity without committing to long-term use.
Can Chickens Safely Eat Mushroom Scraps? A Feeding Guide
You may want to see also
Frequently asked questions
There is no strong scientific evidence to suggest that mushroom supplements directly cause yeast infections. However, individual reactions may vary, and some people might experience imbalances in their microbiome that could potentially contribute to yeast overgrowth.
Mushroom supplements are generally considered safe and do not typically disrupt the body’s fungal balance. They often contain beneficial compounds that support immune health, but it’s always best to consult a healthcare provider if you have concerns.
No specific type of mushroom supplement has been proven to cause yeast infections. However, if you have a history of yeast infections or sensitivities, it’s advisable to monitor your body’s response when introducing new supplements.
If you’re prone to yeast infections, it’s a good idea to consult a healthcare professional before taking mushroom supplements. While they are unlikely to cause issues, individual sensitivities or underlying conditions may warrant caution.

























